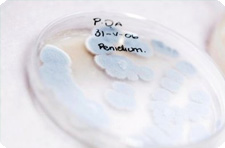

Исследователи отмечают, что это вещество уже применяется во время операций на сердце, оно помогает снизит активность иммунной системы при трансплантации органов пациентов, а также предположительно имеет противоопухолевые свойства. Ученые попытались выяснить, насколько велик омолаживающий потенциал рапамицина. Опыты на мышах показали, что прием рампамицина помогает увеличить предполагаемую продолжительность жизни на 38%. Однако до сих пор непонятно, как это вещество действует. Предполагает, что соединение взаимодействует с белками TOR в клетках, и тело начинает думать, что питание уменьшилось. Многие исследования до этого показали связь между количеством пищи и продолжительностью жизни. Использование медикаментов на основе рампамицина осложняется тем, что это соединение подавляет активность иммунной системы. Однако ученые считают, что это вещество может стать отличной основой для омолаживающей косметики Источник: Новости на cosmomir.ru | |
Похожие новости:
Народное мнение!!!
Последние новости
| |||
| |
| |
| Имеете ли Вы отношение к косметическому бизнесу? |
2024-04-10 17:27:05
Объем экспорта косметики из Южной Кореи установил новый рекорд
2024-04-10 17:18:19
Серена Уильямс запускает свой косметический бренд
2024-04-10 17:11:49
Яна Рудковская сообщила о запуске собственного бренда косметики
2023-12-24 18:28:20
Лионель Месси представит собственный аромат
2023-12-06 11:41:56
Исследование показало, что психосоциальный стресс может быть провоцирующим фактором для обострения акне
2023-11-29 12:47:39
Ароматы из воздуха
2023-11-15 21:50:17
Основные тенденции развития средств по уходу за телом
2023-11-15 21:38:03
6 главных трендов по уходу за телом в 2023 году
2023-11-15 21:32:50
Потребители вправе вернуть даже невозвратные товары
2023-11-15 18:03:16
Певица Адель запускает свой бьюти-бренд
| |||||||||||||||||||||
| ||
В земле на острове Пасхи найдено вещество, которое обладает уникальными омолаживающими свойствами, пишут ученые. Это соединения называется рапамицин.
В земле на острове Пасхи найдено вещество, которое обладает уникальными омолаживающими свойствами, пишут ученые. Это соединения называется рапамицин.









